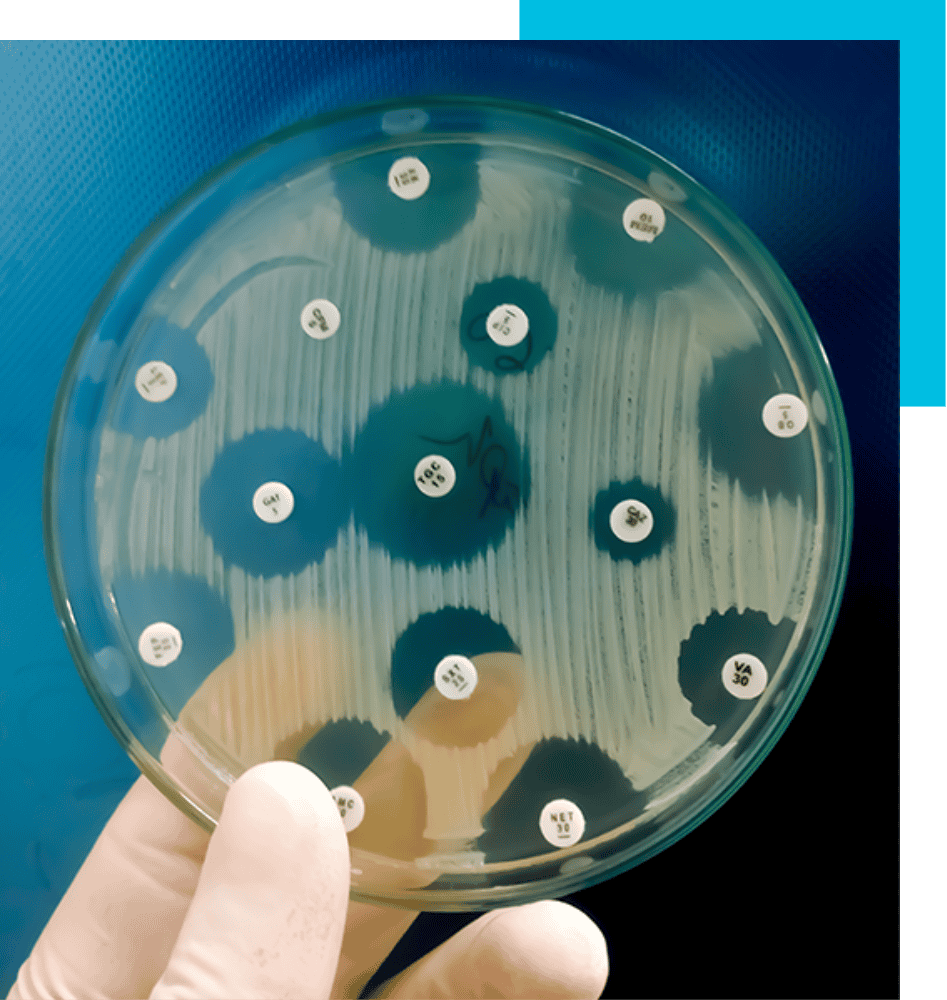

REDEFINE
WOUND CARE STANDARDS
WITH DEBRIX®
Our product is an innovative topical dehydrating agent designed to remove infection and biofilm in hard-to-heal wounds, with a one single 60-second application.

How DEBRIX® Works
DEBRIX® desiccates the biofilm, as well as the residing and planktonic micro-organisms within 60 seconds of application.
By instantly capturing water molecules from any type of exposed biological material, DEBRIX® has an immediate dehydrating effect, with no damage to the vital tissue below the wound bed.
DEBRIX® mode of action on animated wound model
DEBRIX®‘s effect on bacteria
DEBRIX® safe on intact skin
DEBRIX® application process
Core Benefits of Using DEBRIX®
SINGLE APPLICATION
In >90% of cases, granulation is achieved after one-single DEBRIX® application, saving time during the treatment process and expediting wound healing.
EASY AND FAST TO USE
Due to its fast action and applicability outside the surgery room, DEBRIX® can easily be integrated within standard wound care procedures.
SAFE ON INTACT SKIN
DEBRIX® works by withdrawing water from the wound bed materials and due to the low water content of the outer layer of the epidermis, the surrounding healthy skin is not affected.
REMOVES BIOFILM AND INFECTION
DEBRIX® removes the biofilm and infection in a 60 second application. Triggering fast granulation and promoting natural healing.
Core Benefits of Using DEBRICHEM®

Single Application

Easy and Fast To Use

Safe On Intact Skin
Effective For All Ideal For Antibiotic Resistance
DEBRIX® is a dynamic wound care innovation that is ideal for all patients, including those facing antibiotic-resistant challenges. Its chemistry is designed to combat infection without resistance, offering a lasting solution where traditional antibiotics fall short.
Economical and efficient, DEBRIX® simplifies treatment, reduces dependency on costly antibiotics, and accelerates healing across the spectrum of patient needs.

Reduces Chronic Wound Pain
Chronic pain is a major issue for patients living with hard-to-heal wounds. Pain is caused by the infection and inflammation of the wound. By eliminating the infection, patients experience a significant decrease in pain soon after DEBRIX® treatment.
DEBRIX® Application Process
DEBRIX® offers and straightforward and fast application process suitable for ambulatory settings, making it accessible for healthcare professionals: doctors and nurses. Unlike traditional debriding methods, it doesn’t require a specific training.

1. Put on protective gloves and glasses

2. Remove existing wound dressing

3. Rinse wound and periwound with saline

4. Clean and dry the wound surface with a dry gauze

5. If required, apply topical painkiller and remove once the anaesthetic effect has been reached

6. Make sure to remove the topical painkiller before DEBRICHEM

7. Shake the vial with the product before opening

8. Open the vial by removing the screw cap

9. Apply product by pouring generously onto the wound bed and leave on for up to 60 seconds

10. Uniformly spread DEBRIX® on the wound with gloved finger, applying ample pressure

11. Cover the complete wound bed and periwound area

12. After 60 seconds, rinse the wound with ample saline

13. Remove remaining loosened debris with dry sterile gauze

14. Dry the wound with (sterile) gauze

15. Cover the wound according to standard of care
A FAST AND EFFECTIVE
SOLUTION FOR HARD-TO-HEAL WOUNDS
When To Consider DEBRIX®
DEBRIX® can be used by all healthcare professionals in particular wound care specialists, nurses, surgeons, diabetic foot ulcer specialists and vulnologists, to treat all non-surgical hard-to-heal wounds such as:

Diabetic Foot Ulcers

Venous Ulcers

Post-traumatic skin ulcers

Pressure ulcers

Why DEBRIX® Is Safe On Healthy Skin
In contrast viable tissue and healthy skin are protected by membrane lipids exposing lower water content.
This protects the epidermal layer of the surrounding skin from the desiccation effect.
Biofilm is composed of 97% water molecules and microbial aggregates. It is encased within an extracellular matrix of polysaccharides, proteins and glycoproteins.
Cost Efficient Solution
Studies have revealed that DEBRIX® is 57% more cost-effective solution compared to wound care standards. It has the potential of saving millions to healthcare systems.3

Frequently Asked Questions
Topical dehydrating agent intended for non-surgical debridement and treatment of non-surgical infected wounds. The product is intended to be applied by healthcare professionals only.
Biofilm is composed of 97% water molecules and microbial aggregates. DEBRIX® binds water molecules. The acidic principle dissociates and produces protons and anions that bind water molecules and release energy. This process triggers a strong exothermic dehydration process. By instantly capturing water molecules from any type of exposed biological material, DEBRIX® has an immediate dehydrating effect, with no damage to the vital tissue below the wound bed.
DEBRIX® can be used treat all non-surgical hard-to-heal wounds such as:
- Diabetic Foot Ulcers
- Venous Leg Ulcers
- Pressure Ulcers
- Vasculitis Ulcers
- Post-surgical Ulcers
- Post-traumatic Skin Ulcers
- Arterial Ulcers
DEBRIX® should not be used in cases of:
- Schemic ulcers prior to an effective revascularization.
- Neoplastic Ulcers.
- Underlying abscesses or fasciitis which require lancing.
- Underlying osteomyelitis.
- Intolerance for any of the ingredients.
- Allergies to any of the ingredients.
- The safety and performance of DEBRIX® has not been substantiated in pediatric subgroups and in pregnant or lactating women. Physicians should consider alternative options for debridement in these patients.
- Underlying cartilage.
- Dry full thickness non-viable tissue (eschar), unless removed pre-debridement.
DEBRIX® used in combination with NPWT is successful in removing biofilm and necrosis and supports the rapid development of granulation tissue, thus contributing to overall faster healing. According to a recent study involving twelve patients with diverse foot and leg ulcers sheds light on this success. These ulcers varied in type, with an average size of 308 cm2 and an average duration of 13 months. Among them, five were venous leg ulcers, two were arterial, one had a mixed venous/arterial origin, and one stemmed from a post-trauma situation (with an unknown etiology: N=3). Remarkably, all patients achieved complete granulation in an average of 13.2 days.
Read the full article here:
https://www.gavinpublishers.com/article/view/combining-an-acidic-compound-and-npwt--debridement-and-granulation-in-leg-and-foot-ulcers

